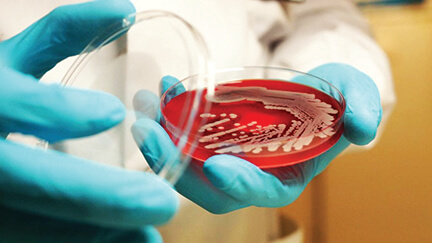

নতুন একটি ব্যাকটেরিয়ার সন্ধান মিলেছে, আকারে যেটি চোখের পাপড়ির সমান। তাই খালি চোখেই সেটি দেখা যায়। সিএনএন জানায়, গত বৃহস্পতিবার ‘জার্নাল সায়েন্স’ সাময়িকীতে প্রকাশিত এক গবেষণা প্রতিবেদনে এমনটি বলেছেন বিজ্ঞানীরা। ক্যারিবীয় অঞ্চলে ফ্রান্সের গুয়াদলুপ দ্বীপের ম্যানগ্রোভ বনে ‘থিওমারগারিটা ম্যাগনিফিকা’ প্রজাতির এ ব্যাকটেরিয়ার সন্ধান মিলেছে। খবর বিডিনিউজের।
এটির দৈর্ঘ্য ২ সেন্টিমিটার পর্যন্ত হতে পারে। আকারে ব্যতিক্রম এ ব্যাকটেরিয়াটির গড় কোষের দৈর্ঘ্য ৯ হাজার মাইক্রোমিটারের বেশি। বেশিরভাগ ব্যাকটেরিয়ার কোষের দৈর্ঘ্য দুই মাইক্রোমিটারের মত হয়। যদিও বড়গুলি ৭৫০ মাইক্রোমিটার পর্যন্ত হতে পারে।
নতুন ব্যাকটেরিয়াটি ঠিক কতটা বড় তা বোঝাতে যুক্তরাষ্ট্রের সমুদ্র জীববিজ্ঞানী এবং বিজ্ঞানী জ্যঁ-ম্যারি ভল্যাদঁ বুধবার সিএনএনকে বলেছেন, এই ব্যাকটেরিয়াটি অন্য প্রজাতির ব্যাকটেরিয়া থেকে কতটা বড় সেটা বোঝাতে আমরা বলতে পারি, এটা মাউন্ট এভারেস্টের সমান লম্বা একজন মানুষ খুঁজে পাওয়ার মত। একটি ‘থিওমারগারিটা ম্যাগনিফিকা’ ব্যাকটেরিয়ার যতটা জায়গা প্রয়োজন, সেখানে অনায়াসে ছয় লাখ ২৫ হাজারের বেশি ই-কোলাই ব্যাকটেরিয়ার জায়গা হয়ে যাবে।
ব্রিটিশ সংবাদমাধ্যম ‘দ্য গার্ডিয়ান’ এর প্রতিবেদনে বলা হয়েছে, নতুন সন্ধান পাওয়া এ ব্যাকটেরিয়ার আকার মানুষের চোখের পাপড়ির সমান। ফ্রান্সের আন্তিলেস বিশ্ববিদ্যালয়ের জীববিজ্ঞানের অধ্যাপক এবং গবেষণা প্রতিবেদনটির সহ-লেখক অলিভিয়ার গ্রস সাংবাদিকদের বলেন, এ আবিষ্কার অণুজীববিজ্ঞানকে অনেক সমৃদ্ধ করবে। ক্যারিবীয় দ্বীপ শহর পয়েন্তে অ্যা পিত্রেতে অলিভিয়ার গ্রসের পরীক্ষাগারে একটি টেস্ট টিউবের ভেতর নতুন এই ব্যাকটেরিয়ার নমুনা রেখে দেওয়া হয়েছে, যা দেখতে চোখের পাপড়ির মতো।
গ্রস বলেন, প্রথমে আমি ভেবেছিলাম এটি আর যাই হোক ব্যাকটেরিয়া নয়। কারণ, ব্যাকটেরিয়া তো দুই সেন্টিমিটার আকারের হতে পারে না।
গবেষকেরা সর্বপ্রথম ২০০৯ সালে এ ব্যাকটেরিয়া শনাক্ত করেন সালফার সমৃদ্ধ ম্যানগ্রোভের পলির ভেতরে। ইলেকট্রনিক মাইক্রোস্কপিসহ বিভিন্ন প্রযুক্তির সহায়তায় পরীক্ষা করে দেখা যায়, এটি ব্যাকটেরিয়ার জীবাণু। তবে এটি এককোষী কি না, তা তখন নিশ্চিত হতে পারছিলেন না বিজ্ঞানীরা। পরে বিজ্ঞানী জ্যঁ-ম্যারি ভল্যাদঁ ক্যালিফোর্নিয়া বিশ্ববিদ্যালয় পরিচালিত লরেন্স বার্কেলি ন্যাশনাল ল্যাবরেটরিতে ওই ব্যাকটেরিয়া নিয়ে গবেষণা করেন এবং শেষ পর্যন্ত প্রমাণ হয়, নতুন সন্ধান পাওয়া ব্যাকটেরিয়াটি এককোষী।